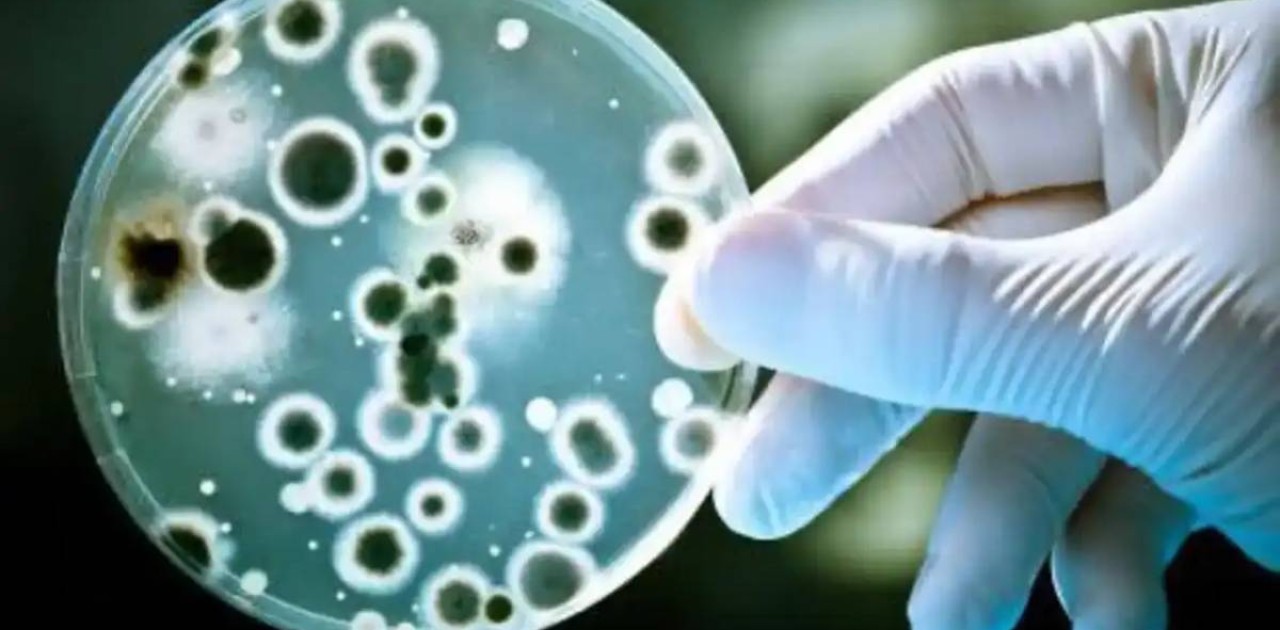
Атырауда мал соятын цех қызметкерінен сібір жарасы анықталды

Атырауда мал соятын цех қызметкерінен сібір жарасы анықталды
Атырауда «Асыл-Агро» мал сою цехының бір қызметкерінен сібір жарасы анықталды, деп хабарлады Elordainfo.kz Ақ Жайық басылымына сілтеме жасап.
Қазіргі уақытта науқас медициналық хаттамаға сәйкес ем қабылдап жатыр. Жағдайы бірқалыпты. Қасында болған басқа адамдардан ауру белгісі анықталмаған.
Естеріңізге сала кетейік, 2024 жылдың 20 қарашасында өлген малдан сібір жарасының табылуына байланысты шаруашылықтың мал сою цехы аумағында карантин енгізілген.
Өлексенің қасында 17 адам болған, олардан инфекция анықталған жоқ. Қазір барлығы инфекционистерге қаралып, динамикалық медициналық бақылауға алынды.
Ветеринариялық бақылау мамандары карантиндік аймақта орналасқан төрт түлікке толық вакцинация жасады. Оған қоса аумақты дезинфекциялау жұмыстары жалғасып жатыр.
Атырау облысына ірі қара мал әкелуді бақылау үшін төрт полиция және ветеринарлық бақылау бекеттері орнатылып, екпе жасалғанын растайтын құжаттар мен малдың жағдайы тексеріліп, термометрия жүргізіліп жатыр. Санитариялық қауіпсіздік мақсатында осындай шаралар Атырау қаласындағы мал сою цехтарында да ұйымдастырылды. Қажетті құжаттарсыз жануарларды тасымалдауға және союға қатаң тыйым салынды.



















































